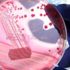
Her 3 kanser vakasından 2'sini önlemek mümkün

MORE IN SAĞLIK»
resimsiz






Bina teknolojilerinin geleceği masaya yatırıldı
06 Şubat 2018 13:52 resimsizDünyanın en önemli gıda fuarı kapılarını açıyor!
06 Şubat 2018 13:52 resimsizGalatasaray'da kupa mesaisi başladı
06 Şubat 2018 13:52 resimsizHastanede korkunç olay: Çocuğunu boğarak öldürmek istedi
06 Şubat 2018 13:52
Neslihan'dan kavga iddialarına fotoğraflı yanıt
06 Şubat 2018 13:52 resimsiziPhone 9 ve Xs için yeni haber var
06 Şubat 2018 13:52 resimsizGiresunspor için Yılmaz Vural sesleri
06 Şubat 2018 13:52
13 yıl sonra dünyaya gelen Rüya'ya, rüya gibi doğum günü kutlama…
06 Şubat 2018 13:52 resimsiz14 ilde operasyon: 20 rütbeli asker gözaltında
06 Şubat 2018 12:47
Jandarma, 160 kaçak göçmeni yakaladı
06 Şubat 2018 12:07
Açık renkli gözlülerde göz kanseri riski daha yüksek
06 Şubat 2018 11:47
Acillerdeki bekleme süresi kısaldı
06 Şubat 2018 11:47
Her 3 kanser vakasından 2'sini önlemek mümkün
06 Şubat 2018 11:47HOTTEST NEWS IN SAĞLIK»
WHAT'S NEW IN SAĞLIK»
- Pfizer'ın koronavirüs hapı için lisans anlaş…
- Belçika'da aşı yaptırmayan sağlık personelin…
- Kepez DokumaPark'ta botanik bahçe açıldı
- Kayapınar Belediyesi'ne ‘TS EN ISO 9001 Kali…
- Manisa'da prestij cadde düzenlemeleri sürüyor
- Serik'te trafik kazası : 3 yaralı
- Karantinayı ihlal eden 2 kişi trafik uygulam…
- Kıbrıs Gazisi Yılmaz son yolculuğuna uğurlan…
- Ormanda üzerine ağaç devrilen Hakan öldü
- Burcu Esmersoy'un akşam yemeği şıklığı
- Pfizer, Kovid-19'a karşı ağızdan alınan ilaç…
- Covid-19'a yakalanan hamilelerde erken doğum…
- AB Adalet Divanı'ndan yargı bağımsızlığı kon…
- Doğumu kolaylaştıran yeni teknik literatüre …
- Sivas'ta doğumu kolaylaştıran teknik: Bilim …
- Türkiye'nin koronavirüs aşılama kampanyası k…
- Corona aşısından sonra sıra kanserde
- Koronavirüs erken doğum riskini arttırıyor
- "Fazla dezenfektan cilt kuruluğuna neden olu…
- Bilim Kurulu üyesinden 3. doz açıklaması!


